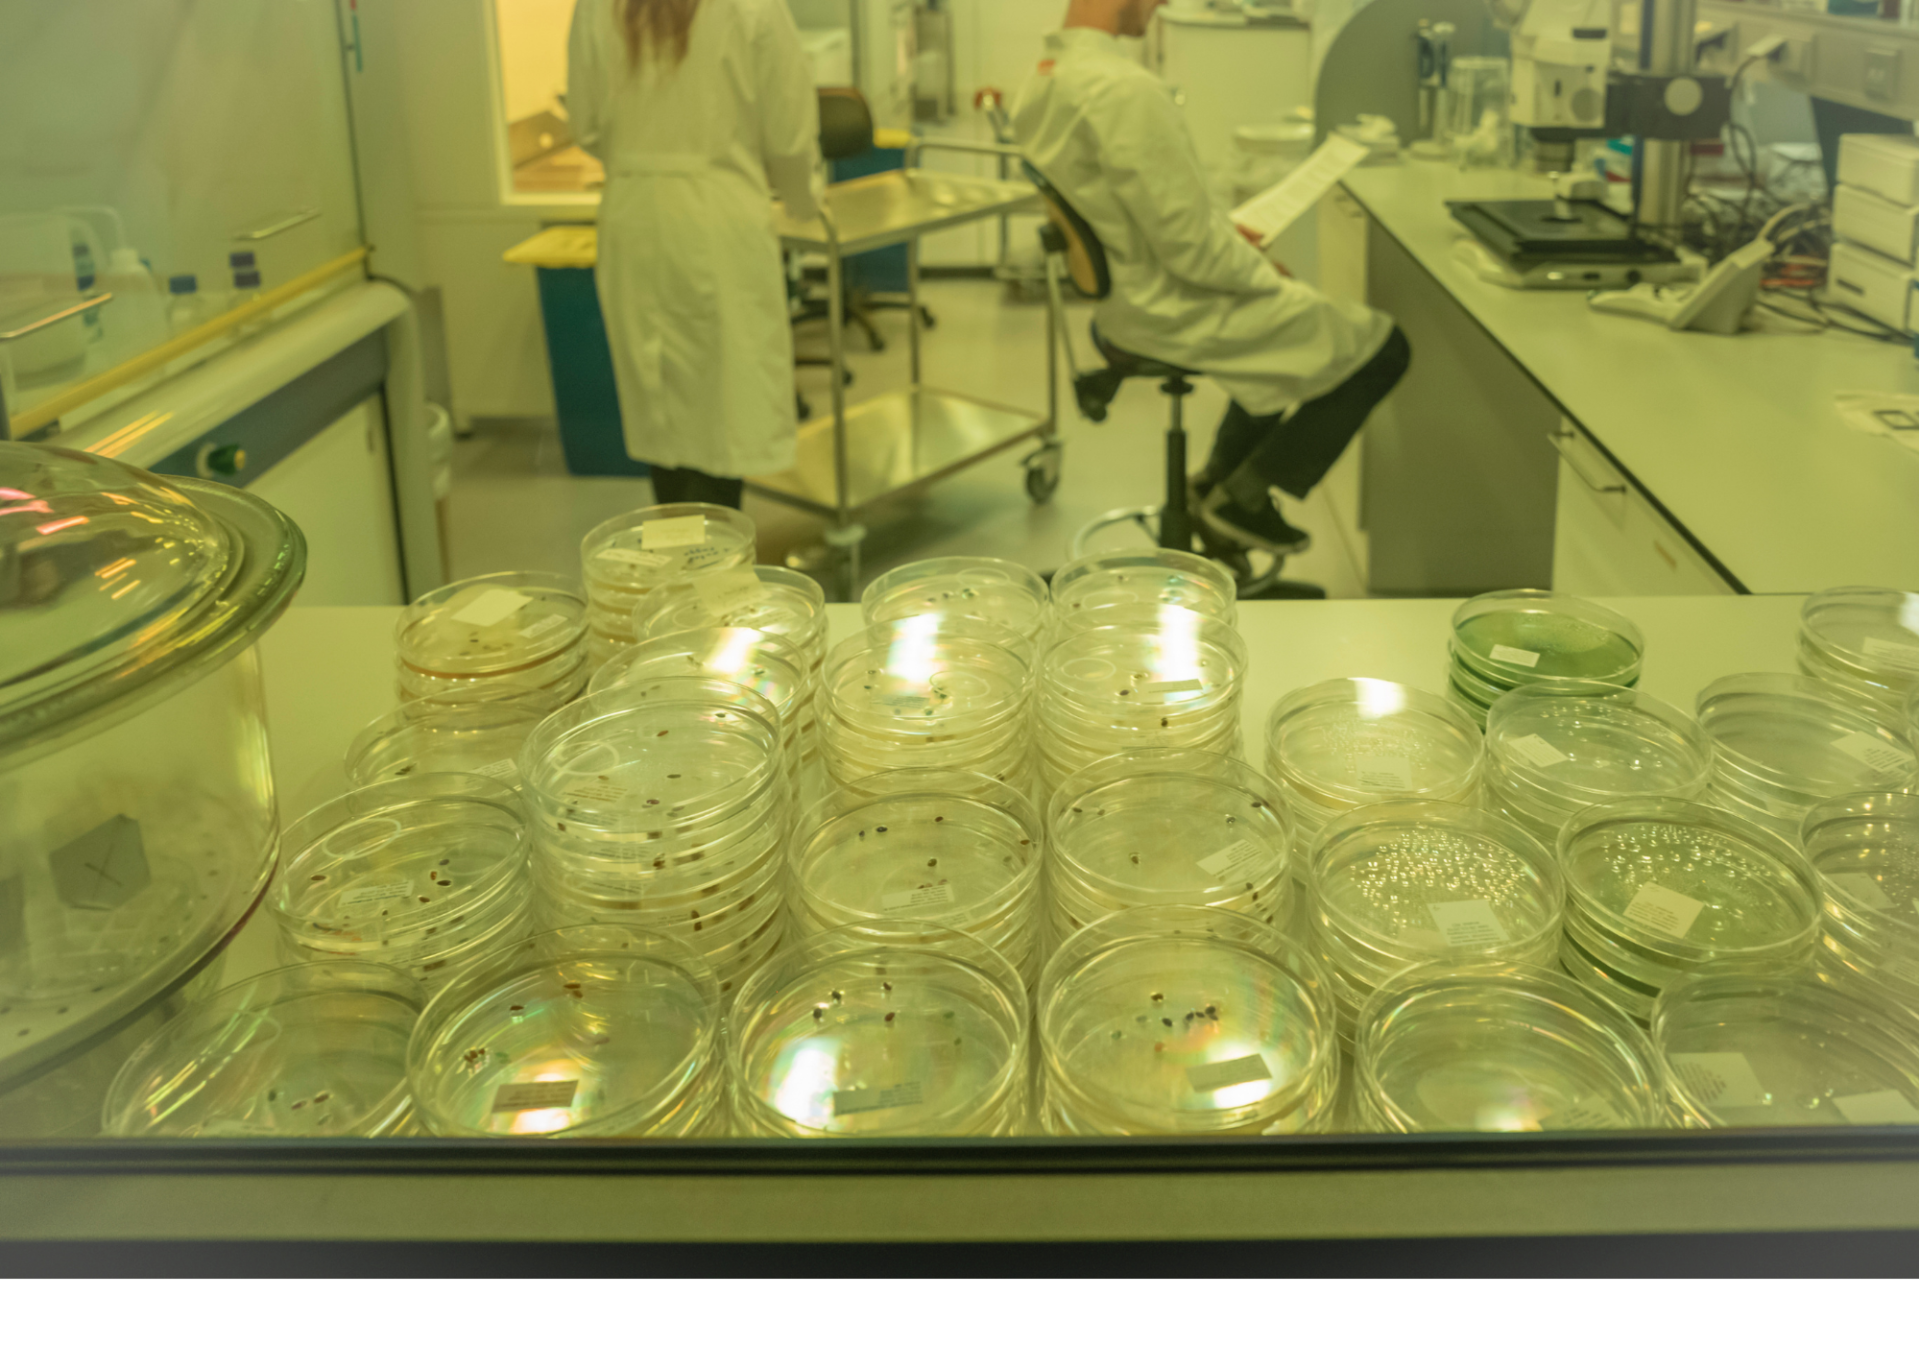

Za više ravnoteže u tijelu.
EM-X Gold® nazivaju i eliksirom života.
EM-X Gold® direktno utjeće na imunitet.
EM·X Gold® - originalni je napitak -profesor dr. Teruo Higa
Drugim riječima,
EM-X Gold® tijelu daje ogroman poticaj za samoizlječenje,
direktnim utjecajem na naš imunitet.
Kako koristiti ?
•
pripremljenu količinu napitka možete konzumirati u toku cijelog dana polako ili odjedanput u jutro ili prije spavanja
•
preporuka je otvorenu bocu potrošiti naj duže u roku 8 tjedana (2 mj.)
• čuvati na udaljenom mjestu od dosega Sunca ili u frižideru - po izboru
Koliko dugo konzumirati ?
Efektivni Mikroorganizmi su sastavni dio našeg tijela.
Preporuka je konzumirati ih preventivno ili kao terapiju (u većem omjeru) minimum 6 mj.
Kontinuirano i svakodnevno - ako se žele vidjeti rezultati.
Kako čuvati ?
• ne izlagati napitak sunčanoj svjetlosti
• bocu odložiti na tamnije mjesto
• idealno sobna temperatura bez velikih oscilacija
• kod početka konzumacije, kad jednom otvorite napitak, najbolje je piti ga kontinuirano dok se ne potroši. Ne čuvati za kasnije.
Rok trajanja ne otvorenih boca je godinu dana. Kasnije još ima djelovanje ali sve manje i manje, kroz vrijeme.
Kako pripremiti EM · X Gold® za konzumaciju?
- Otvorite bocu
• Odvojite planiranu količinu EM · X Gold®a u zasebnu čašu
• prelite pripremljenom vrućom vodom.
• Idealna temperatura vruće vode za aktivaciju EM · X Gold®.a je 80 C.
• Planiranu količinu EM · X Gold®.a možete aktivirati i na način da je direkno ulijete u vruču šalicu čaja, u vruču juhu ili varivo...
Zagrijavanjem (aktivacijom) EM · X Gold®.a dolazi do povećanja djelovanja.
Potencijal i djelotvornost aktiviranog napitka ne gube se postepenim hlađenjem u toku dana. Snaga ostaje ista popije li se odjednom topao ili se pije kroz dan rashlađen.
Kako dozirati ?
• Naj bolji način konzumiranja EM · X Gold®.a za očuvanje zdravlja,
prema Profesoru dr. Teruo Higa je
5-20 ml EM·X Gold®.a na dan (1 do 4 čepa)
1 čep dnevno = 100 dana
1 čep cca 5 ml
•1 boca EM · X Gold® sadržaja je od 500 ml (100 čepova);
•pokrivenost jedne boce = je od 1-2-3 mjeseca ovisno koju količinu konzumirate.
Iz prakse:
• kod alergija poput peludne groznice preporuka je
- 10 - 15 ml na dan (2 do 3 čepa).
• kod autoimune bolesti npr/reumatizam preporuka je
- 25-45 ml dan (5 do 9 čepova).
• maligne bolesti, jake srčano-žilne bolesti preporuka je
- 60-90 ml dan (12 do 18 čepova).
- Ponekad se savjetuje više od 90 ml/dnevno za posebno životno opasna stanja.
• Kada je prisutna VELIKA kiselost organizma (posebno ozbiljne dijagnoze)
u praksi se konzumira od 2 do 9 boca EM·X Gold®.a mjesečno
što znači od 50 ml do 1,5 dcl na dan min 6 mj.
Nakon toga ovisno o postignutom stanju organizma postupno se smanjuje količina unosa.
Mogućnosti primjene
i Rok trajanja
jer ne sadrži konzervanse.
Rok trajanja uvijek je naveden na dnu.
Ne pijte izravno iz boce,
već iz čaše, posude za hranu/vodu ili prskajte direktno u usta pipetom ili štrcaljkom. (izvor: udruga EM)
Više o EM·Gold®.u
EM·X Gold®
•
poboljšava kvalitetu krvi
•
utječe na staničnom nivou i potiče regeneraciju.
Ukratko utječe na cijeli organizam i to na način da:
•
dubinski utječe na smanjenje broja slobodnih radikala
•
vraća organizmu vitalnost i zdravlje
•
regulira PH
EM・X GOLD®
napitak je "proizveden" snagom fermentacije.
Za razliku od tipične fermentirane hrane,
EM・X GOLD® ne sadrži žive mikroorganizme,
bez laktoze je,
bez glutena
i bez kalorija.
Štoviše, zbog velikog broja spojeva niske molekularne težine, EM・X GOLD® ne opterećuje želudac čak ni kada ste umorni
ili se ne osjećate dobro, bez obzira na dob.
Ne izaziva nikakve alergijske reakcije.
Ništa ne djeluje tako efikasnoi brzo kaokao EM·X Gold®._EM·X Gold® ima "vidljiv" učinak i kod zdravih osoba.
Važno je istaknuti da EM · X Gold® napitak;
• kod primjene nema nikakvih kontraindikacija
• ima jak preventivni učinak
• oporavak je puno brži
• SVAKA TERAPIJA uz paralelnu konzumaciju EM®a je učinkovitija.
• Nema nikakvih kontraindikacija u kombinaciji s lijekovima prepisanim od strane liječnika. Dapače, oporavak može biti puno jednostavniji i brži.
Ljudi u suvremenom svijetu podvrgnuti su stresu, raznim prikrivenim i štetnim dodacima unutar vode/hrane što može uzrokovati neravnotežu unutar tijela (kiselost) samim tim dugoročno može doći i do stvaranja bolesti.
EM・X GOLD® vraća ravnotežu vašem tijelo , na prirodan način.
EM・X GOLD®
- fermentacijski napitak -
Što to znači!
Napitak je na bazi metabolita niske molekularne mase.
Zbog niske molekularne mase ti metabolati pokreću niz kemijskih reakcija direktno unutar naših stanica (pokreću se prirodni metabolički procesi).
EM® (probrani regenerativni mikro-organizmi) bazni je element EM Tehnology®.e.

.
Ključni sastav svakog probiotičkog pripravka na tržištu su mikro-organizmi.
Osnovna razlika između pripravaka prisutnih na tržištu je količina, vrste mikro-organizama unutar pripravaka tj raznolikost-mikroorganizama unutar jednog pripravka.
Što je "paleta raznolikosti veća" (više sojeva) to je veća i "paleta djelovanja".
Najčešće su na tržištu
prisutni pripravci od 1-12 soja (vrste)
mikro-organizama.
EM®
predstavlja revoluciju
u znanosti i medicini
jer sadrži metabolate
čak iz 80 sojeva (vrsta) mikro-organizama.
Ne sadrži žive mikro organizme i s toga se ubraja u ANTIALERGIJSKI PRIPRAVAK.

.
Živi mikro-organizmi naseljavaju naš probavni sustav
kao i cijeli naš organizam.
Dijelimo ih na dobre i loše ovisno koriste li našem zdravlju ili ne.
Efektivni mikroorganizmi (EM®) posebno su aktivni i dragocjeni, jer imaju sposobnost
prenošenja
određenih zadataka
na druge mikro-organizme
i tako stvaraju
jaku "branu" protiv patogenih mikro-organizama.
Pod EM® zaštitnim znakom
nalazi se
formula za izgradnju imuniteta
kako odraslih, tako i djece
od najranije životne dobi.

.
EM•X Gold® Jak je anti-oksidant
Jak anti-oksidant znači da se aktivno pridonosi oporavku organizma.
-
Osnovna zadaća EM·X Gold®.a je
zaštita i jačanje imuniteta.
-
Posebno dobro djeluju protiv gljivica,parazita i bakterija u svim dijelovima našega tijela,
vrlo čestih uzročnika bolesti
(npr. gljivica Candide albicans, bakterija E.Coli...),
što je dokazano kroz dugogodišnju primjenu
i kroz mnoštvo nezavisnih znanstvenih istraživanja a ključna činjenica je da se EM tehnologija® primjenjuje već 40 godina u Svijetu.
Ukratko o EM·X Gold®u - prevedena brošura s engleskog.

.
Tri razine djelovanja EM·X Gold®
1. Anti-oksidacija;
štite stanice i tvari od oksidacije i propadanja.
2. Deionizacija;
oslobađa oksidirane tvari iz naboja,
što omogućuje štetnim tvarima da napuste tijelo.
3. životna Vibracija;
• Oslobođeni štetni naboj, kroz vibraciju
pretvara se u pozitivni naboj.
-
dostupna je tijelu zajedno s energijom koja se oslobađa vibracijom;
tijelo koristi za funkcionalne i regenerativne procese.
Učinci ;
Učinjeno je puno temeljnih i nezavisnih istraživanja.
Da bi prosječan čovjek donekle razumio koliko u dubinu seže naše zdravlje u nastavku pročitajte neke od informacija koje su ključne za razumijevanje;
Zašto ili kako dolazi do bolesti !?
Ulazimo u sfere: mikrobiologije, kemije, fizike, ulazimo u sfere "duboke" znanosti.
Anti-oksidans
Što su ANTI-OKSIDANSI?
• molekule sposobne za usporavanje oksidacije drugih molekula.
ŠTO JE OKSIDACIJA unutar našeg tijela?
• Oksidacija je kemijska reakcija
u kojoj dolazi do prijenosa elektrona ili vodika
unutar stanica
a prilikom tih prijenosa mogu nastati slobodni radikali.
KOJA JE ULOGA EM · X Gold®.a?
• EM · X Gold® direktno utječe na smanjenje slobodnih radikala
unutar našeg organizma
i samim tim utječe na jačanje našeg prirodnog imunološkog sustava.

Slobodni radikali
stvaraju lančanu reakciju unutar stanice,
a kada dođe do lančane reakcije u stanici, može biti prouzročena šteta ili može doći do uništenja same stanice.

Najveća snaga EM·X Gold®.a
dolazi od činjenice da ima individualni učinak unutar svakog organizma;
EM · X Gold® odmah počinje djelovati i djeluju gdje treba i koliko treba.

Deionizacija
Što znači DEIONIZACIJA unutar organizma?
Proces razgradnje stvara štetne tvari koje ostaju unutar organizma zbog svog električnog naboja.
Koja je uloga EM · X Gold®a u deionizaciji?
EM · X Gold® uklanja taj naboj i "otpadni materijal" napušta tijelo uz pomoć vode.
Vibracije
Koja je uloga EM·X Gold®.a na vibraciju unutar stanice?
-
EM·X Gold® generira (proizvodi) trodimenzionalne vibracije
pri čemu nastaje
izravno korisna regenerativna energija.
Štetna se energija postepeno apsorbira i pretvara u pozitivnu energiju.
Na kojoj razini djeluje EM·X Gold®?
Što je baza EM·X Gold®.a?
Da ponovimo;
U bazi EM · X Gold®.a su Efektivni Mikro-organizmi®
Njih 80 vrsta u više miliunskim količinama.
Ti regenerativni mikro-organizmi zajedno, u simbiozi, stvaraju učinkovite tvari (metabolite),
neophodne za očuvanje funkcija unutar organizma.
EM · X Gold® ne sadrži žive mikroorganizme.
EM · X Gold® sadrži njihove metabolite, niske molekularne mase što omogućava napitku da djeluje direktno na stanicu.

Što sadrži EM · X Gold®?
sadrži stvorene učinkovite tvari (metabolite) koji se naknadno izdvajaju iz baze EM®.
Ti metaboliti
male molekule koje direktno učestvuju na normalan rast, razvoj i reprodukciju stanica
uključuju minerale u tragovima, vitamine i enzime.

Koja je tajna uspjeha EM·X Gold®a na organizme?
Pojedinačne molekule u EM·X Gold®u su znatno manje od proteina koji se obično unose hranom.
95% molekula u EM·X Gold®u,
stanice tijela izravno apsorbiraju
i na taj način razvijaju svoj mehanizam djelovanja.

Što je EM · X Gold®
EM · X Gold® je tekućina.
Znanje je patentirano još davne 1982 u Japanu.

Sastojci se odabiru posebno pažljivo, ne samo zbog očuvanja kvalitete,
već i zbog dodatnih elemenata potrebnih da bi se povećala i unaprijedila sama snaga EM · X Gold®.a.

EM·X Gold® je skup sekundarnih tvari
nastalih u kontroliranim uvjetima od probranih, regenerativnih, živih mikro-organizma.
Ukratko:
EM·X Gold® je "koktel učinaka"
koji se odmah pokreću unutar sustava (organizma) kad uđe u njega.

ŠTO SU sekundarni proizvodi
i simbioza mikro-organizama?
Posljednjih godina manje se proučava aktivnost jednog soja mikroorganizama, a više agregati mikroorganizama, koje nazivamo mikro-biomi.
Postalo je očito da MIKROBIOMI, obogaćuju tijelo domaćina.
Vodeni mikro-biomi pomoći će kod pročišćavanja okoliša u rijekama i drugih voda.
Mikro-biomi tla pomoći će kod regeneracije i oplemeniti će tlo.
Kao u okolišu,
mikr-obiomi
prisutni su unutar ljudskog tijela kao i izvan tijela (nokti, dlaka i koža) .

Više o mikrobnoj flori domaćina pročitajte na

IMUNOLOŠKI SUSTAV
EM·X Gold® ima utjecaj i djeluje na naše zdravlje preko našeg imuno sustava.

Metabolički proizvodi učinkovitih mikroorganizama čine učinak EM·X Gold®a posebnim.
Poticanje fermentacije (zagrijavanjem) EM®-a
srce je EM® pristupa i rezultat dugogodišnjeg istraživanja.
TKO ŽELI RAZUMJETI VIŠE
o utjecaju mikrobiote na naše zdravlje!
Acta medica Croatica : Časopis Akademije medicinskih znanosti Hrvatske, Vol. 73 No. 1, 2019.
(Uvodnik i sažetak)

LJUDSKA MIKROBIOTA, MIKROBIOM
I BOLESTI CRIJEVA kod djece
Mikro-biotu čovjeka čine svi mikroorganizmi koji žive u simbiozi s ljudskim tijelom, a humani mikro-biom sadrži i do stotinu puta veći broj gena negoli ljudski genom.
Iako mikroorganizme možemo naći u raznim nišama ljudskog tijela, najbrojnija je mikro-biota probavnog sustava.
Mikro-biota je varijabilna među zdravim ljudima i jedinstvena za svakog pojedinca jer na nju utječe mnoštvo različitih čimbenika.
I dalje je nepoznanica što je točno zdrava mikro-biota, ali poznate su neke od njenih uloga u odvijanju fizioloških procesa u stanju zdravlja.
S druge strane, u slučaju narušene ravnoteže unutar mikro-biote, (disbioze) može doći do razvoja bolesti.

Disbioza unutar organizma
često se povezuje s nastankom brojnih patoloških stanja od kojih su najviše istražena:
• pretilost,
• kronične upalne bolesti crijeva,
• sindrom iritabilnog kolona,
• kolo-rektalni karcinom,
• alergijske bolesti djece te
• bolesti usne šupljine...
Razvoj metoda u proučavanju mikr-obiote dovelo je do boljeg razumijevanja interakcije populacija (sojeva) nepatogenih mikroorganizama međusobno,
i sa svojim domaćinom.
Razvojem metoda u proučavanju otvoren je autoput razumijevanju utjecaja mikr-obiote na razvoj bolesti i primjene modifikacija mikr-obiote
u preventivne
i terapijske svrhe.
Za više razumijevanja preporučamo da pogledajte PDF u prilogu.
Prve mikrobiome
dobivamo prilikom rođenja.
Trudnice i trudnoća zasebna su tema koju ovdje zasebno ne obrađujemo.
Dobro je biti upoznat.

Za više informacija o mikrobiomu koji se razvija od trudnoće do ranog djetinjstva - preporučamo da pročitate:
Mikrobna flora prisutna je u svakom kutu našeg organizma a ne samo u crijevima
i ima ključnu ulogu u funkcioniranju našeg organizma.

Naše tijelo je ili alkalno ili kiselo.
Kako bismo bili zdravi,
dobro se osjećali i
s lakoćom obavljali svakodnevne poslove,
pH nam mora biti neutralan
ili blago alkalan
-
između 7,3 i 7,5.

Zbog suvremenog načina života naše tijelo je kiselije.
Što uzrokuje:
umor,
bezvoljnost,
anksioznost,
nadutost,
općenito loše stanje
Kiselost organizma je i "okidač" za mnoge bolesti.

Kako bi tijelo moglo apsorbirati i iskoristiti pojedine hranjive tvari koje unosimo prehranom, probavni sustav treba hranu valjano razgraditi.
Nezdrave prehrambene navike,
poput prevelikog unosa hran
s kojom se probavni sustav ne može nositi,
uzrokuju probavne tegobe,
a probavne tegobe
štetno djeluju na odnos kiselosti unutar našeg tijela.
Alkalno i neutralno znači topivo, standardno prihvatljivo
Kiselo u ovom slučaju predstavlja loše i ne prihvatljivo u količinama
Acidifying znači zakiseljavanje.
RJEŠENJE:

Rješenje;
EM · X Gold®,
BIOTA zdravlja
- rješava tj. ublažava kiselost organizma
na prirodan način.
Nadoknađuje potrebne metabolite tj. molekule koje su odgovorne za rast, razvoj i reprodukciju stanica unutar domaćina.

EM · X Gold®
stvara povoljnu klimu za oporavak i ozdravljenje.
Pomaže organizmu pri "izbacivanju" slobodnih radikala i pri postizanju balansa unutar mikro flore domaćina.

Kakav je učinak EM · X Gold®a i brzina djelovanja
I učinak i brzina direktno su povezani u prvom redu s
trenutnim zdravstvenim stanje domaćina,
količini EM®a koja se konzumira i
vremenskim periodom konzumiranja (mjesec, dva mj ili godina...)

EM · X Gold®a počinje djelovati
ODMAH.

Početna veća doza EM·X Gold®, kod početka primjene može potaknuti čišćenje crijeva unutar 24 sata, tj. može doći do pojave mekše stolice. Nakon prvog čišćenja, probava će se vratiti u normalu.
Savjet:
EM·X Gold® napitak ima velik učinak i izvana, direktno na koži.
Utjecaj EM·X Gold®a je antiparazitski, antibakterijski i antivirusni.
Štiti od infekcija
i ubrzava prirodnu regeneraciju.
Da biste to učinili nabavite mali džepni raspršivač u ljekarni. Mnogi korisnici koriste pripravak za prskanje po licu prilikom rada za računalom ili direktno u usta.
Sastav EM·X Gold®:
voda,
melasa,
kvasac,
magnezijev klorid dobiven iz morske vode.
Hrana za mikroorganizme
unutar EM·X Gold®

Prirodni sadržaj minerala i elemenata u tragovima u "hrani za mikroorganizme" igraju veliku ulogu u proizvodnji EM·X Gold®-a, kao i njihova jaka energetska svojstva.
Dugogodišnja istraživanja otkrila su da su minerali posebno vrijedna hrana za EM® s toga jedan od elemenata EM·X Gold®-a je koraljni kalcij

Koraljni kalcij: Koraljni kalcij Sango koralja, koristi se za EM·X Gold®, koji se ekstrahira iz fosilnih grebena u dubokim, netaknutim morskim slojevima.
Prirodno je bogat kalcijem, a sadrži i magnezij, natrij i kalij.

Magnezijev klorid porijeklom iz prirodne morske vode, poznat i kao Epsomova sol (japanski "Nigari").
Nigari je tekući dio morske vode koji ostane nakon ekstrakcije svih kristalnih soli.
Uz magnezij, Nigari ima vrlo visok udio i drugih minerala.

Melasa šećerne trske nusproizvod je proizvodnje šećera i služi kao hrana učinkovitim mikroorganizmima.
Bogata je mineralima, aminokiselinama i organskim kiselinama koje podržavaju rast mikroorganizama.

Ekstrakt kvasca * - posebno je bogat proteinima, aminokiselinama, ugljikohidratima, vitaminima i mineralima, a time i hranom za mikroorganizme.
Kvasac je dio naše prehrane stoljećima.

Proces fermentacije u tri faze
pojam koji u kemiji i biologiji označava pretvaranje određenih organskih spojeva putem djelovanja enzima.
Ostali mikrobi se hrane tim komponentama i proizvode druge, manje komponente.
Taj se postupak ponavlja nekoliko puta, tako da se stvaraju sve manje komponente. Te uzastopne djelomične fermentacije nazivaju se i "kraljevskim putem fermentacije" kako bi se postigao optimum u probavi.
Aktivne komponente koje se proizvode na kraju lančane fermentacije ključni su elementi EM·X Gold®-a .

Ovim je EM·X Gold® spreman vratiti naše zdravlje u ravnotežu. Učinak je dokazan u kliničkim studijama.

Od EM·X® do EM·X Gold®
Desetljeća iskustva i istraživanja djelotvornih mikroorganizama prof. dr. Hige otišla su u EM·X Gold®
Nakon EM®a došlo se do verzije EM·X®a nekoliko godina kasnije poboljšavanjem nastao je EM·X Gold®.
EM·X Gold® je trenutno treća generacija novog eliksira, u kojem je prof. dr. Higa uspio ukombinirati sve tri razine EM® aktivnosti.
Tijekom stalnog istraživanja kroz desetljeća, došlo je do današnjeg EM·X Gold®-a. Prof.dr. Higa je otkrio da je osobito učinkovito hraniti mikroorganizme na razini minerala kako bi mogao iskoristiti njihov potencijal vibracija.
Izvorni minerali iz dubokog mora imaju najveću energetsku učinkovitost na proizvod.

Zaključak
EM·X Gold® ne sadrži nikakve aditive, konzervanse ili arome.
EM·X Gold® je fermentacijsko piće koje sadrži samo korisne tvari iz prirodnih sirovina.

Da bi nastao EM·X Gold® napitak,
prvo je morala nastati EM Technology®
Pod vodstvom EM® istraživačke organizacije (EMRO),
uporaba EM-1® BIOTE brzo se proširila na 140 zemalja Svijeta
i stalno se radi na poboljšanju.
EM® je razvio profesor dr. Teruo Higa, tadašnji profesor doktor, danas u mirovini, još uvijek aktivan kao predavač, emeritus na Sveučilištu Ryukyus u Okinavi. Predavač na svjetskim simpozijima znanosti i zdravlja
.

Osvrnemo se na našu bazu našeg postojanja i opstanka
RNA i DNA

Deoksiribonukleinska kiselina (kratica) DNA
DNA stanica je nukleinska kiselina.
U obliku dvostruke spiralne zavojnice.
Većina DNA je smještena u staničnoj jezgri.
Ubraja se u osnovnu molekulu nasljeđivanja,
Odgovorna je za prenošenje nasljednog materijala i osobina.
Za vrijeme diobe
stanice DNA se replicira
i prenosi se (potomcima) reprodukcijom.
Ribonukleinska kiselina (simbol RNA),
RNA je biološki važan tip molekula.
Sastoji se od dugih kovalentno vezanih (vrsta kemijske veze pri kojoj svaki atom daje po jedan elektron, koji čine zajednički elektronski par, koji pripada objema jezgrama i time povezuje atome) jedinica nukleotida.
Svaki se nukleotid sastoji od dušične baze, šećera riboze (pentoze) i fosfatne skupine.
RNA veoma je slična DNA.
Razlikuje se u nekoliko važnih strukturnih detalja.
Razlika između RNA i DNK:
RNA u stanicama sastoji se od jednog lanca dok je DNA dvo-lančana (dvostruka uzvojnica).
RNA nastaje prenošenjem podataka s DNA pomoću enzimâ koji se nazivaju polimeraze RNA, a dalje se reproducira preko drugih enzima.
Uloga RNA u sintezi bjelančevina je nezamjenjiva.
U tom procesu vrsta RNA, koja se naziva transportna RNA (tRNA) prenosi informacije sadržane u vidu aminokiselina s DNA na strukture koje se nazivaju ribosomi. Ovi ribosomi su načinjeni od bjelančevina i ribosomske RNA , koje zajedno formiraju molekularni stroj za čitanje, prijenosne RNA i provođenje informacija koje ona prenosi u bjelančevine.
Postoji mnogo vrsta RNA s različitim ulogama:
Molekula RNA i danas u biologiji ima vrlo važnu ulogu, ponajprije u osnovnim i evolucijski očuvanim staničnim procesima.
Služi kao glasnička molekula (mRNA) koja sudjeluje u prijenosu genetičke informacije od jednog ili više gena do ribosoma, gdje će se sintetizirati odgovarajući protein. Sastavni je dio ribosoma (rRNA) te «čita» informaciju kodiranu u glasničkoj RNA i prenosi odgovarajuću aminokiselinu na rastući polipeptidni lanac tijekom sinteze proteina (tRNA).
U replikaciji DNA,
RNA služi kao baza.
Direktno je uključena u postranskripcijsku doradu primarnih transkripata i sudjeluje u regulaciji ekspresije gena. Drugim riječima; uključena je u prenošenje informacija iz gena i sudjeluje i njihovom provođenju.
Čini se vrlo vjerojatnim da je pra-molekula života, bila upravo RNA molekula, no ostaju još brojna pitanja oko razvitka RNA svijeta i njegove kompleksnosti, te prelaska u današnji svijet s DNA genomima i proteinskim enzimima.

Studija Mamdooh Ghoneum, imunologa na sveučilištu medicine i znanosti u Drew, Kalifornija, pokazuju da
EM · X Gold®
stimulira aktivnosti RNA-stanica,
Aktivnost RNA stanica
vrlo je bitan faktor
u pokušaju kontrole raka te za
Aktivnost RNA stanice direktno utječe na aktivnosti imunološkog sustava unutar samih stanica te
preko molekularne razine postiže jako djelovanje na cijeli organizam.

Kako bi što lakše shvatili djelovanje mikroorganizama na organizam domaćina,
konkretno krv,
pogledajte sljedeći video.
VAŽNO I DA PONOVIMO;
EM·X Gold® napitak nema nuspojava, koje mogu negativno utjecati na zdravlje.

Prirodno, bez-GMO.
Znamo da je Lijek pripravak koji smanjuje simptome bolesti, sprječava širenje bolesti
ili liječi potpuno.
Lijek može biti prirodnog ili sintetičkog (umjetnog) porijekla. Naj veći dio izrađenih lijekova su sintetičkog porijekla, proizvedeni u laboratoriju.
Za razliku od klasične medicine,
EM · X Gold® je prirodan pripravak.
Dostupan samo pod zaštićenim nazivom EM®.
Originalni pripravak obavezno ima prisutnu oznaku ® uz EM (efektivni mikroorganizmi).
Uvijek prisutan i istaknut originalni naziv EM® i naziv efektivni (ne učinkoviti) - garancija su izvornosti i kvalitetu napitka profesora, dr. Teruo Higa.e
EM® nastao je, razvija se i proizvodi se samo u Japanu, u strogo kontroliranim uvjetima.
U istom obliku prisutan je u 140 zemalja svijeta
a može ga se nabaviti i u Hrvatskoj.

Na temelju svog nezavisnog istraživanja, dr. Okezie Aruoma (Predsjednik i glavni izvršni direktor Global PharmHealth Investors Inc, glavni urednik American Journal of Biopharmacy and Pharmaceutic Sciences,Long Beach, Kalifornija, Sjedinjene Američke Države)
zaključuje:
Ja mogu reći da tretman s EM·X®.om može imati blagotvoran učinak na osobe koje pate od bolesti poput
Alzheimerove bolesti,
MS,
epilepsije,
Parkinsonove bolesti,
demencije,
karcinoma.
Sva se istraživanja zapravo svode na istu stvar: EM·X GOLD® je prirodan i posjeduje ga svaki organizam tj. sadržaj EM·X GOLD®.a je prisutan u svakom zdravom tijelu.

Tu je još jedan razlog zašto se EM · X Gold® ne reklamira kao lijek
i nikada po životnoj filozofiji prof. dr. Teruo Higi ni neće.
Prof. dr. Tanaka Higa ne želi da EM · X Gold® bude
niti postane službeni lijek zbog životnih stavova.
On kaže;
"Kad bi EM·X® postao klasičan lijek bilo bi ga moguće dobiti samo na recept i koristiti bi ga jedino mogli kad odete do liječnika i kada vam ga prepiše. Ne želim dopustiti da se stvari tako razvijaju.
Vidim zdravlje kao nešto za što smo osobno odgovorni.
Za vaše zdravlje nije odgovoran liječnik, ili netko drugi.
To znači da ako se radi o vašem zdravlju sami biste trebali jesti zdravo, pa čak i poduzeti preventivne radnje kad god to smatrate potrebnim.
Ako bi radili na tome da EM·X® bude priznati lijek, to bi došlo u suprotnost s mojom filozofijom. "


Osim zdravog tijela
nužan je i što zdraviji okoliš
u kojem obitavamo.
Za ekološko čišćenje prostora pročitajte:

stranica od
EMRO-Japan
više o samom WM X GOLDu na eng.
Međunarodna stranica za EMX Gold
Izjava o odricanju odgovornost: Informacije sadržane na ovoj internet stranici namijenjene su isključivo općem znanju i nisu zamjena za profesionalni medicinski savjet ili liječenje za specifična zdravstvena stanja. Posavjetujte se s pružateljem zdravstvenih usluga u vezi bilo kakvih pitanja ili nedoumica u vezi s vašim stanjem.
Izbor tema
Izjava o odricanju odgovornost: Informacije sadržane na ovoj internet stranici namijenjene su isključivo općem znanju i nisu zamjena za profesionalni medicinski savjet ili liječenje za specifična zdravstvena stanja.
Posavjetujte se s pružateljem zdravstvenih usluga (liječnicima) u vezi bilo kakvih pitanja ili nedoumica.












